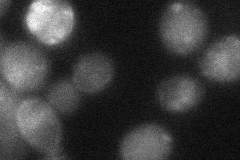
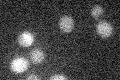

View description
Inducible high-affinity maltose transporter (alpha-glucoside transporter); encoded in the MAL1 complex locus; member of the 12 transmembrane domain superfamily of sugar transporters; broad substrate specificity that includes maltotriose
Localization:
Intensity:
Fold change:
Significance:
-
C’ GFP library in SD

below threshold16.72 -
N' NOP1pr-GFP in SD

cell periphery,vacuole76.3023 -
N' TEF2pr-mCherry in SD

vacuole114.222 -
N' NATIVEpr-GFP in SD

below threshold15.1416 -
N' TEF2pr-VC and Cyto-VN in SD
punctate29.0891 -
C’ GFP library in SD+DTT

cytosol14.020.83No -
C’ GFP library in SD+H2O2

cytosol14.560.87No -
C’ GFP library in Starvation Media
cytosol15.510.92No -
C’ GFP library on the background of Pup2-DaMP

below threshold -
C’ GFP library on the background of CCT mutant

below threshold15.79160.943795No
